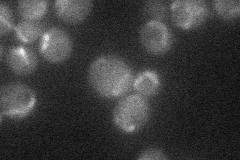

View description
NADH:ubiquinone oxidoreductase, transfers electrons from NADH to ubiquinone in the respiratory chain but does not pump protons, in contrast to the higher eukaryotic multisubunit respiratory complex I; phosphorylated; homolog of human AMID
Localization:
Intensity:
Fold change:
Significance:
-
C’ GFP library in SD

below threshold15.59 -
N' NOP1pr-GFP in SD
mitochondria23.483 -
N' TEF2pr-mCherry in SD

below threshold6.22992 -
N' NATIVEpr-GFP in SD

below threshold17.4291 -
N' TEF2pr-VC and Cyto-VN in SD

#N/A0 -
C’ GFP library in SD+DTT

cytosol18.061.15No -
C’ GFP library in SD+H2O2

cytosol16.411.05No -
C’ GFP library in Starvation Media

cytosol15.210.97No -
C’ GFP library on the background of Pup2-DaMP

N/A -
C’ GFP library on the background of CCT mutant

N/A0N/AYes
